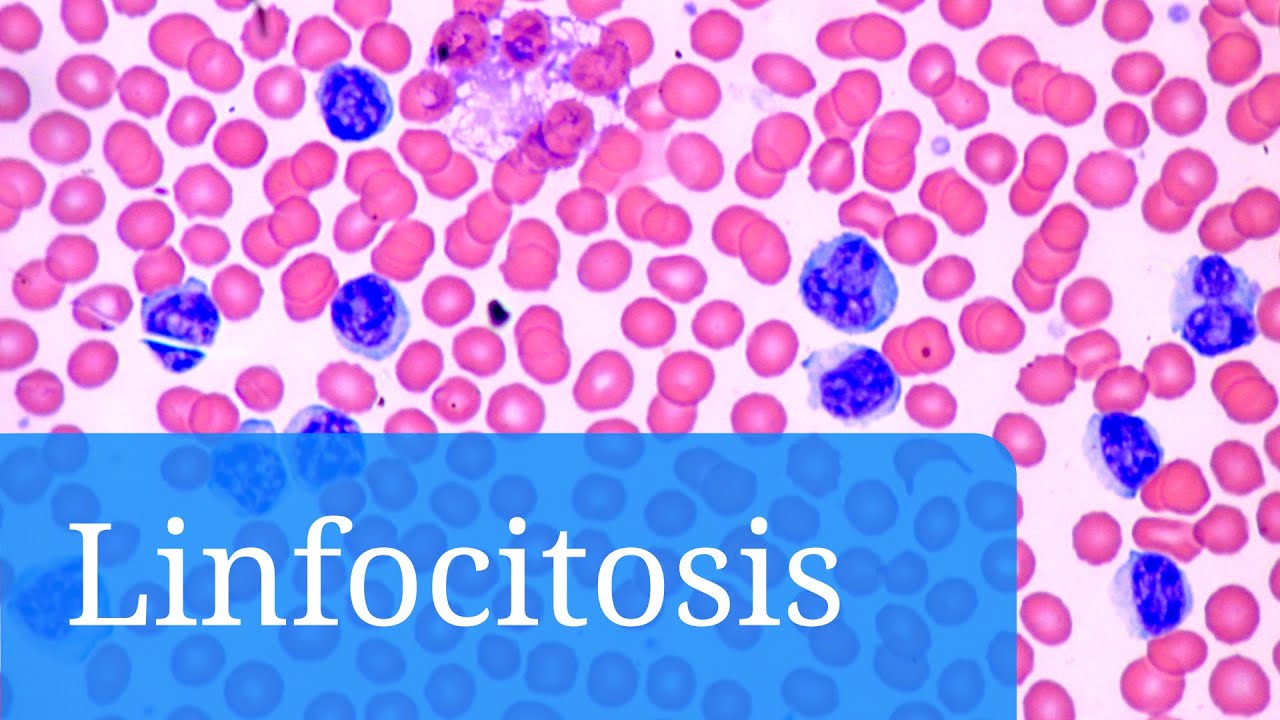
que pasa si tienes los linfocitos altos

¿Qué pasa si tienes los linfocitos altos? Causas, síntomas y tratamiento
Los linfocitos son un tipo de glóbulo blanco crucial para el sistema inmunológico, encargado de combatir infecciones y enfermedades. Sin embargo, cuando los linfocitos se encuentran elevados, esto puede ser un indicativo de diversas condiciones de salud que requieren atención. En este artículo, exploraremos en profundidad qué significa tener linfocitos altos, sus posibles causas, los síntomas que pueden acompañar a esta situación y las opciones de tratamiento disponibles. Comprender esta condición no solo es vital para tu salud, sino que también puede ayudarte a tomar decisiones informadas en colaboración con tu médico. Acompáñanos en este recorrido informativo y descubre todo lo que necesitas saber sobre los linfocitos altos.
¿Qué son los linfocitos y cuál es su función?
Para entender qué pasa si tienes los linfocitos altos, primero es fundamental conocer qué son y cuál es su papel en nuestro organismo. Los linfocitos son un tipo de glóbulo blanco que juega un papel esencial en el sistema inmunológico. Se producen en la médula ósea y se dividen principalmente en tres tipos: linfocitos T, linfocitos B y células NK (Natural Killer).
Tipos de linfocitos
- Linfocitos T: Son fundamentales en la respuesta inmune adaptativa. Ayudan a identificar y destruir células infectadas o cancerosas.
- Linfocitos B: Se encargan de producir anticuerpos que neutralizan patógenos como bacterias y virus.
- Células NK: Actúan de manera rápida contra infecciones virales y tumores, sin la necesidad de una activación previa.
Los linfocitos son esenciales para mantener la salud y prevenir enfermedades. Un recuento normal de linfocitos oscila entre 1,000 y 4,800 células por microlitro de sangre. Cuando este número supera los niveles normales, hablamos de linfocitosis, una condición que puede indicar la presencia de diversas patologías.
Causas de los linfocitos altos
Existen múltiples causas que pueden llevar a un aumento en el recuento de linfocitos. Es importante señalar que no todas las elevaciones son motivo de alarma, pero sí merecen ser evaluadas por un profesional de la salud. A continuación, exploramos algunas de las causas más comunes.
Las infecciones virales son una de las causas más frecuentes de linfocitos altos. Cuando el cuerpo detecta un virus, el sistema inmunológico responde aumentando la producción de linfocitos. Algunas infecciones virales que pueden provocar este aumento incluyen:
- Mononucleosis infecciosa: Causada por el virus de Epstein-Barr, se caracteriza por fiebre, dolor de garganta y fatiga.
- Hepatitis: Inflamación del hígado que puede ser causada por varios virus, como el hepatitis A, B o C.
- Infecciones por citomegalovirus: Común en personas con sistemas inmunológicos comprometidos.
Enfermedades autoinmunes
Las enfermedades autoinmunes, donde el sistema inmunológico ataca células sanas del cuerpo, también pueden resultar en un aumento de linfocitos. Ejemplos de estas enfermedades son:
- Lupus eritematoso sistémico: Afecta múltiples sistemas y órganos, causando inflamación y daño.
- Artritis reumatoide: Inflamación crónica de las articulaciones que puede llevar a daño articular.
Condiciones malignas
En algunos casos, los linfocitos altos pueden ser un signo de enfermedades malignas, como leucemias o linfomas. Estas condiciones requieren un diagnóstico y tratamiento inmediato. Los linfomas, por ejemplo, son cánceres que afectan el sistema linfático y pueden presentarse con síntomas como pérdida de peso, sudores nocturnos y fiebre.
Síntomas asociados a los linfocitos altos
La linfocitosis en sí misma no suele presentar síntomas específicos, pero puede estar acompañada de manifestaciones de la enfermedad subyacente. Conocer estos síntomas puede ayudarte a identificar cuándo es el momento de buscar atención médica.
Fatiga y debilidad
Uno de los síntomas más comunes asociados a un aumento de linfocitos es la fatiga. La sensación de cansancio extremo puede ser el resultado de una respuesta inmune activa a una infección o enfermedad. Este tipo de fatiga no se alivia con el descanso y puede interferir significativamente con las actividades diarias.
Fiebre y sudores nocturnos
La fiebre es una respuesta común del cuerpo a infecciones y enfermedades. Si experimentas fiebre persistente junto con linfocitos altos, es crucial consultar a un médico. Los sudores nocturnos, que pueden ser incómodos y perturbadores, también son un síntoma que a menudo se relaciona con condiciones como linfomas o infecciones virales.
Otros síntomas
Además de la fatiga y la fiebre, pueden presentarse otros síntomas, tales como:
- Pérdida de peso inexplicada
- Dificultad para respirar
- Dolores en el cuerpo o articulaciones
Diagnóstico de linfocitos altos
El diagnóstico de linfocitos altos comienza con un análisis de sangre que evalúa el recuento de glóbulos blancos. Si los resultados muestran un aumento en los linfocitos, el médico puede solicitar pruebas adicionales para determinar la causa subyacente. Estas pruebas pueden incluir:
Pruebas de sangre adicionales
Las pruebas de sangre adicionales pueden ayudar a identificar infecciones, marcadores autoinmunes o indicios de cáncer. Por ejemplo, un hemograma completo puede proporcionar información sobre otros componentes de la sangre y ayudar a establecer un diagnóstico más claro.
Biopsia de médula ósea
En casos donde se sospecha una enfermedad maligna, se puede realizar una biopsia de médula ósea. Este procedimiento implica tomar una muestra de tejido de la médula ósea para analizar la presencia de células anormales o cancerosas.
Imágenes médicas
Las imágenes médicas, como radiografías o tomografías computarizadas, pueden ser útiles para detectar inflamaciones o masas en el cuerpo que podrían estar asociadas con un aumento de linfocitos.
Tratamiento para los linfocitos altos
El tratamiento para los linfocitos altos depende de la causa subyacente. No hay un tratamiento específico para la linfocitosis en sí, sino que se enfoca en abordar la enfermedad o condición que la está causando. A continuación, se presentan algunas opciones de tratamiento según la causa:
Tratamiento de infecciones
Si los linfocitos altos son resultado de una infección viral, el tratamiento puede incluir:
- Reposo y cuidados en casa: En la mayoría de los casos, el cuerpo puede combatir la infección por sí solo, y se recomienda descansar y mantenerse hidratado.
- Medicamentos antivirales: En algunas infecciones virales, se pueden prescribir antivirales para ayudar a combatir la enfermedad.
Tratamiento de enfermedades autoinmunes
Para enfermedades autoinmunes, el tratamiento puede incluir:
- Medicamentos inmunosupresores: Estos medicamentos ayudan a reducir la actividad del sistema inmunológico.
- Antiinflamatorios: Para aliviar síntomas como dolor e inflamación.
Tratamiento de condiciones malignas
Si se diagnostica una condición maligna, el tratamiento puede incluir:
- Quimioterapia: Utiliza medicamentos para destruir células cancerosas.
- Radioterapia: Usa radiación para eliminar células cancerosas.
- Trasplante de médula ósea: En casos de leucemia o linfoma avanzado, este procedimiento puede ser necesario.
Preguntas Frecuentes (FAQ)
1. ¿Los linfocitos altos siempre son peligrosos?
No necesariamente. Un aumento en los linfocitos puede ser una respuesta normal a infecciones, pero siempre es importante investigar la causa subyacente. Consulta a un médico si tienes preocupaciones.
2. ¿Qué debo hacer si me dicen que tengo linfocitos altos?
Lo más importante es seguir las indicaciones de tu médico. Puede que necesites realizarte más pruebas para determinar la causa del aumento y recibir el tratamiento adecuado.
3. ¿Se pueden prevenir los linfocitos altos?
No hay una forma específica de prevenir la linfocitosis, ya que muchas de las causas son infecciosas o relacionadas con enfermedades autoinmunes. Sin embargo, mantener un estilo de vida saludable puede fortalecer tu sistema inmunológico.
4. ¿Qué pruebas se realizan para verificar los linfocitos altos?
Generalmente, se realiza un hemograma completo. Si se detectan linfocitos altos, se pueden hacer pruebas adicionales como análisis de sangre específicos, biopsias o estudios de imagen para identificar la causa.
5. ¿Los linfocitos altos pueden causar síntomas por sí mismos?
La linfocitosis en sí misma no suele causar síntomas, pero puede ser un signo de una condición subyacente que sí cause síntomas. Es fundamental evaluar el contexto clínico completo.
6. ¿Hay tratamiento específico para linfocitos altos?
No hay un tratamiento específico para la linfocitosis. El tratamiento se enfoca en la causa subyacente, ya sea una infección, enfermedad autoinmune o condición maligna.
7. ¿Cuándo debo preocuparme por mis linfocitos altos?
Debes preocuparte si experimentas síntomas como fiebre persistente, pérdida de peso inexplicada o fatiga extrema. En estos casos, es crucial buscar atención médica para una evaluación adecuada.